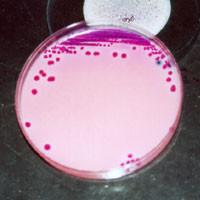

Efforts to monitor prevalence were hampered by failure to tag most cases with correct diagnostic codes.
Fonte: Rate of Antibiotic-Resistant Infections Doubled Since 2002
Efforts to monitor prevalence were hampered by failure to tag most cases with correct diagnostic codes.
Fonte: Rate of Antibiotic-Resistant Infections Doubled Since 2002
Bactéria gram-negativa representa até metade de todas as infecções da corrente sanguínea, mas pouco se sabe sobre a duração efetiva mais curta da terapia, e as recomendações de diretrizes não existem fora das infecções do fluxo sanguíneo relacionadas ao cateter gram-negativo, para as quais a recomendação é 7- 14 dias. Além disso, a utilidade de hemoculturas de seguimento para infecções gram-negativas da corrente sanguínea não é clara, mas pode ter implicações para a utilização de recursos de saúde e o uso de antibióticos. Dois estudos recentes [1,2] abordaram essas questões.
Fonte: Therapy Duration and Follow-up Blood Cultures in Bacteremia


Retirado da atualização de jan/2018 do Sanford Guide.
WHO is recommending that farmers and the food industry stop using antibiotics routinely to promote growth and prevent disease in healthy animals.
Fonte: Stop using antibiotics in healthy animals to preserve their effectiveness
Não é tão simples assim. O consumo de antimicrobianos na indústria de alimentos, especialmente na de frangos, é mais de 100 x maior do que na medicina humana. E para piorar, eles migraram da doxiciclina para a ciprofloxacina e mais recentemente até para a polimixina B, que são colocadas na ração dos pintinhos para previnir pneumonia, que seria inevitável dentro do sistema de criação intensiva atual. Parar de usar essas drogas significa mudar a matriz de produção de fonte proteica de baixo custo para as populações mais pobres do mundo todo. Só isso…
New drugs and new classes intrigue IDWeek audience
Fonte: Antibiotic Pipeline Overflows | Medpage Today
SAN DIEGO — In what one participant called scientific “speed dating,” physicians and researchers here got a rapid-fire look at 10 antibiotics that could be on pharmacy shelves within months.

Skin and soft tissue infections (SSTIs) carry significant economic burden, as wellas morbidity and mortality, especially when caused by methicillin-resistant Staphylococcusaureus (MRSA). Several new MRSA-active antibiotics have been developed, includingsemisynthetic glycopeptides (telavancin, dalbavancin and oritavancin). Of these, dalbavancinand oritavancin offer extended dosing intervals.

Experts in infectious diseases are advising physicians to reconsider advising patients to complete their course of antibiotics.
Fonte: No Evidence Stopping Antibiotics Early Increases Resistance
Beleza!! Mais uma das nossas convicções indo por água abaixo. Bem que um antigo professor ensinava: “A medicina é uma ciência de verdades absolutas, porém efêmeras” (muito provavelmente essa citação é um plágio descarado de Vinícius de Moraes).
Frustrated by the slow development of new antibiotics? Paul Auwaerter, MD, offers a quick review of some of the latest approaches to this problem.
Fonte: No New Antibiotics? Go to the Attic, Build Better Mousetraps
Belíssima revisão, infelizmente em inglês, sobre a estratégia atual de reciclar antimicrobianos antigos e fora de uso, para enfrentar aquele que é considerado um dos problemas mais preocupante da infectologia nos dias de hoje, as infecções por germes multirresistentes. Vale a pena ler.

Antibiotic use in early to mid-adulthood was associated with an increased risk of developing colorectal adenomas later in life, a new observational study has found.
Fonte: Antibiotic Use Linked to Later Colorectal Polyp Formation
Resumindo: intervenções no microbioma intestinal, mesmo que bem intencionadas, não passarão incólumes,